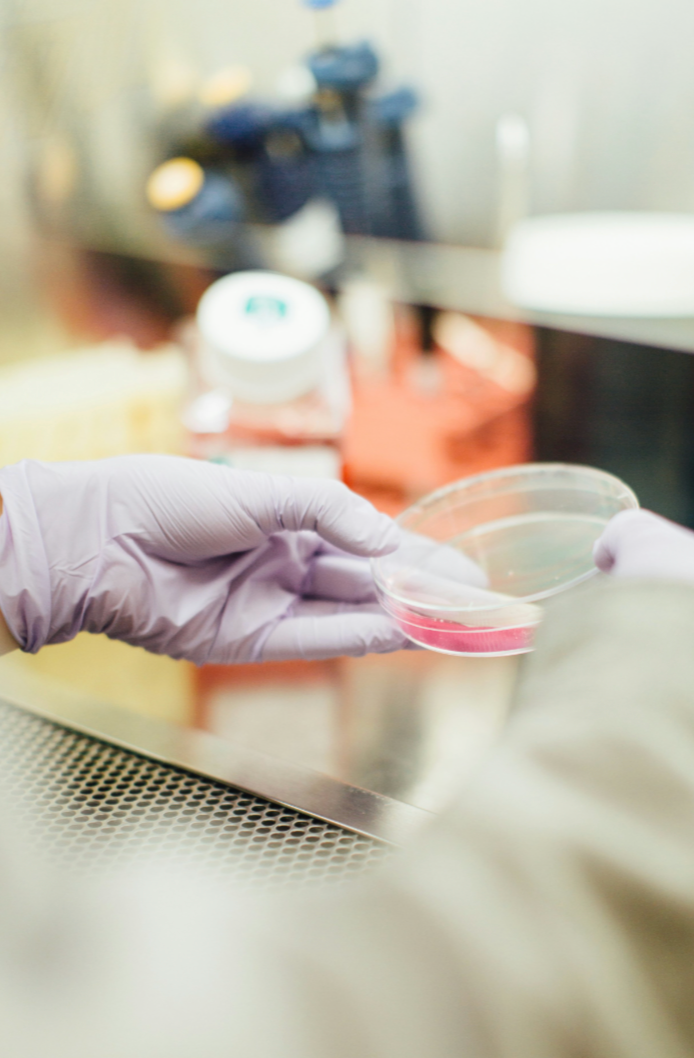
Advancing Women's Health: Bridging Research Gaps and Breaking Barriers

Advancing Women's Health: Bridging Research Gaps and Breaking Barriers
Share
The article from Non Profit Quarterly by Tonie Marie Gordon discusses the health disparities faced by women, including higher rates of heart disease, lung cancer, ovarian cancer, and cervical cancer, which are often underdiagnosed due to insufficient targeted research and screenings. The White House Initiative on Women’s Health Research aims to address these issues with a $100 million investment to advance prevention, detection, and treatment of women’s health conditions. However, despite past efforts by the NIH and FDA, the lack of enforcement and regulatory power raises concerns about the initiative’s potential impact. The article calls for stringent guidelines, persistent monitoring, and accountability to ensure women's unique health needs are effectively addressed and to prevent high mortality from treatable diseases. Read more here.